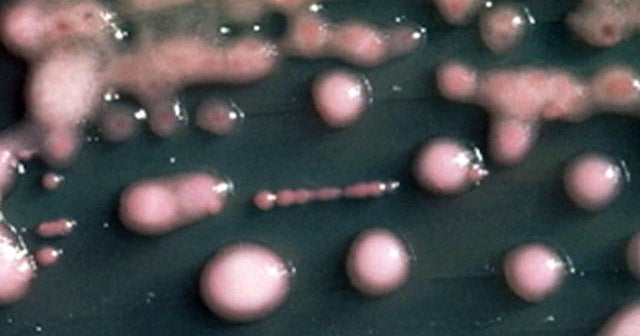
Superbug at UCLA Medical Center could have role in two deaths

Hence then, the article about superbug at ucla medical center could have role in two deaths was published today ( ) and is available on CBS News ( Middle East ) The editorial team at PressBee has edited and verified it, and it may have been modified, fully republished, or quoted. You can read and follow the updates of this news or article from its original source.
Read More Details
Finally We wish PressBee provided you with enough information of ( Superbug at UCLA Medical Center could have role in two deaths )
Last updated :
Also on site :
- James Van Der Beek’s widow says late actor still guides their children in emotional Father’s Day post
- These fruits and veggies are considered the best and worst for your health. Some may surprise you
- Jeremy Clarkson pondered ‘just disappearing’ from Clarkson’s Farm amid cancer diagnosis